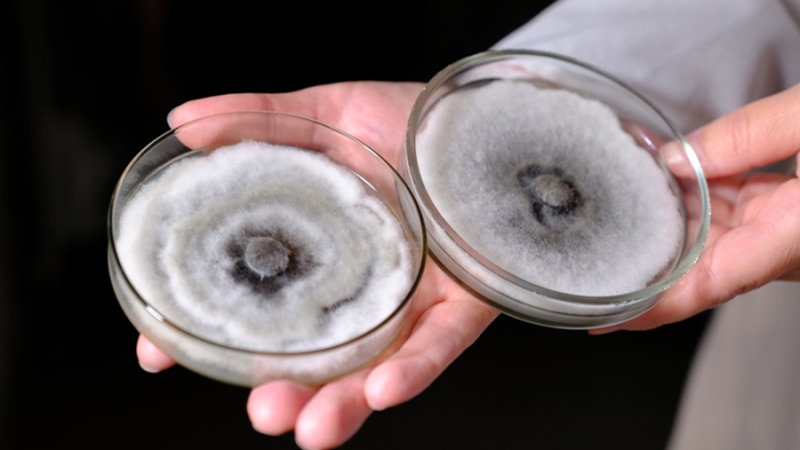

Грибы Красноярск Деревья Ученые 
Следите за нашими новостями в удобном формате Есть новость? Присылайте!
Опасный патогенный гриб хвойных пород (Diplodia sapinea P. Karst) впервые обнаружили в Сибири. Он вызывает некроз сосны и ее последующую гибель, сообщает пресс-служба Красноярского научного центра СО РАН.
Три штамма гриба нашли на соснах разного возраста в парках Красноярска. Организм оказался быстро распространяющимся и вызывающим обширные некротические поражения у деревьев.
Как отмечает ИА KrasnoyarskMedia, ранее гриб встречался только в местах с мягким климатом, например, в Южной Африке и Новой Зеландии. Последнее десятилетие рост числа вспышек наблюдался и в Европе.
Ученые выяснили, что найденный в краевой столице гриб-вредитель показал высокую устойчивость к холоду. Эксперимент показал, что его жизнеспособность сохраняется даже при –31°С.
По словам исследователей, данный вид гриба может распространяться на новые территории и растения-хозяева. Это связано с длительной бессимптомной фазой у патогена, при которой деревья остаются без видимых повреждений. Такие высокие адаптивные возможности позволяют возбудителю оставаться необнаруженным при транспортировке растений и их фрагментов.
Ранее сообщалось, что ученые нашли эффективный способ для борьбы с сибирским шелкопрядом, который приводит к усыханию и гибели хвойных деревьев. Для этого нужно заразить гусениц вредителя двумя разными паразитами.